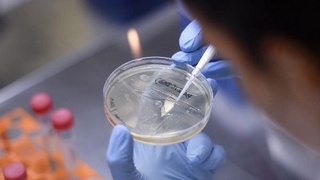
Rossiyada ishlab chiqarilgan vaksinaning narxi qancha?

JSST COVID vaksinasining ilgʻor 6 ta sinovini eʼlon qildi
Vaksina masalasida millatchilik yomon va bu bizga yordam bermaydi.

Vaksina masalasida millatchilik yomon va bu bizga yordam bermaydi.

Yaponiyalik olimlar ipak qurti lichinkasidagi oqsildan COVID-19ga qarshi vaksina ishlab chiqarish ustida bosh qotirishmoqda.

Koronavirusga qarshi vaksinani shoshilib joriy etish koʻpgina sogʻlom odamlarning sogʻligini xavf ostiga qoʻyishi mumkin.

JSST rahbari mamlakatlar va hukumatlarni koronavirus tarqalishining oldini olish uchun zarur choralarni ko‘rishga chaqirdi.

Koronavirusning yangi turiga qarshi yaratilgan vaksina hali bolalar uchun qo‘llanilmaydi, chunki qonunga ko‘ra, preparat avval kattalar uchun to‘liq sinovdan o‘tishi kerak.

ISMI mutaxassislari koronavirusga qarshi vaksinalarni ishlab chiqarish jarayonida aholining ushbu vaksinalarga boʻlgan ishonchi muhim ahamiyat kasb etishini taʼkidlashmoqda.

Virusning yangi turiga qarshi vaksinalarning samaradorligi hali isbotlanmaganiga qaramay, ularning katta qismi allaqachon boy mamlakatlar orasida tarqatilgan.

Rossiya sog'liqni saqlash vaziri Mixail Murashko mamlakatda koronavirusdan himoyalovchi ilk vaktsina ustidagi klinik sinovlar nihoyasiga etganini ma'lum qildi.

Tengrinews.kz saytining 24.kz telekanaliga tayanib bergan maʼlumotiga koʻra, Qozogʻistonda ilk bor koronavirusga qarshi emlash ishlari Qozogʻiston milliy agrar universitetidagi Xal...
RNC Pharma analitik kompaniyasining rivojlanish boʻyicha direktori Nikolay Bespalov Sputnik radiosiga bergan intervyusida koronavirus vaksinasining narxi qancha boʻlishini aytdi.

Bu safargi sinovlarda 30 ming atrofidagi koʻngilli qatnashadi. Ular odatdagidek ikki guruhga boʻlinadi. Birinchi, dorilar bilan, ikkinchisi platsebo orqali yuboriladi.

Bu savolga Bi-bi-sining tibbiyot masalalari boʻyicha muharriri Mishel Roberts javob beradi.